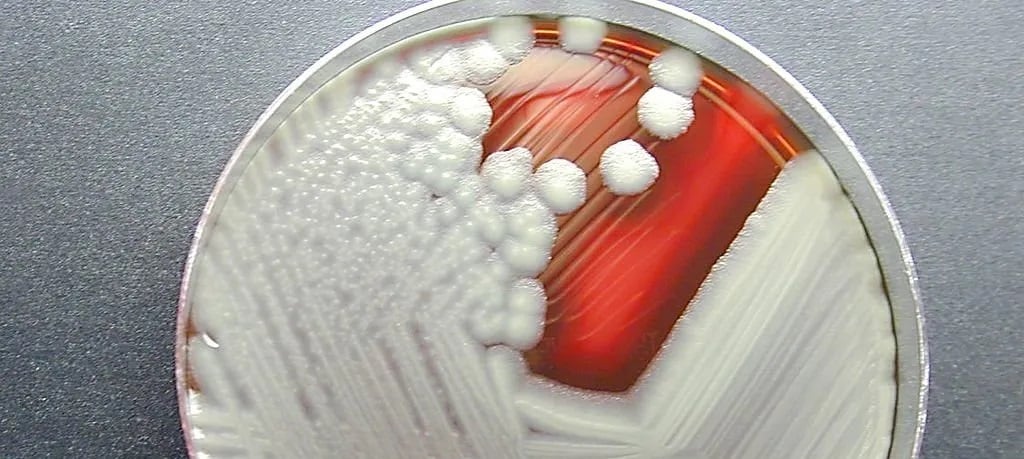

SFA investigating potential presence of cereulide toxin in Nestlé infant formula
Nestlé Singapore has advised customers to follow the Singapore Food Agency’s (SFA’s) guidelines after five batches of its infant formula were stopped from sale.
SFA is investigating the potential presence of cereulide toxin in these batches, it said in a media release on Thursday (8 Jan).

Source: Nestlé FamilyNes Singapore on YouTube
All 5 batches are from Switzerland
The five batches of infant formula and follow-on formula that were stopped from sale are:
- NAN HA 3 SupremePro 800g, Batch 53030017C1
- NAN HA 2 SupremePro 800g, Batch 51420017C4
- NAN HA 1 SupremePro 800g, Batch 51460017C2
- NAN HA 1 SupremePro 800g, Batch 51470017C1
- NAN HA 3 SupremePro 32g, Batch 53030017B1
All of them are from Switzerland, with expiry dates of 31 May 2027 except for the NAN HA 3 800g, which expires on 31 Oct 2027, and the NAN HA 3 32g, which expires on 31 Oct 2026.
Consumers can contact their point of purchase for enquries about the products.
Parents shouldn’t feed affected products to children: SFA
SFA said parents who have purchased the affected products should not feed them to their children.
Children who have consumed the products should be sent for medical attention promptly if they feel unwell.
While there have been no confirmed cases of illness in Singapore from consuming the affected infant formula yet, the Communicable Diseases Agency is conducting surveillance with hospitals to monitor any potential cases of cereulide poisoning in children.
This follows an alert from the European Commission Rapid Alert System for Food and Feed on 7 Jan, and another alert from the International Food Safety Authorities Network on 8 Jan.
Toxin may cause nausea, vomiting, abdominal cramps & diarrhoea
SFA said cereulide is a toxin produced by some strains of Bacillus cereus bacterium.
Source: Sure-BioChem Laboratories
It may cause symptoms such as nausea, vomiting, abdominal cramps, and diarrhoea.
These symptoms typically appear from 30 minutes to six hours of consumption, and will usually resolve within 24 hours.
However, vulnerable individuals like infants and immunocompromised persons have a higher risk of complications.
3 out of 5 batches removed since end-Dec
In a press release on Friday (9 Jan), Nestlé said the Swiss company had implemented precautionary measures proactively, including checking its stocks thoroughly.
It updated that three out of the five batches — the NAN HA 2 SupremePro and two batches of NAN HA 1 SupremePro — were removed as a precaution since the end of last month.
Nestlé added that they are no longer available for sale.
The remaining two batches of NAN HA 3 SupremePro have not been distributed and cannot be found in stores.
“All five batches have undergone thorough testing,” it noted.

Source: Google Maps
Nestlé committed to collaboration with SFA
Nestlé said its information and test results are being shared with SFA and the company remains “committed to ongoing transparency and collaboration” with the agency.
It is also committed to “the highest standards of product safety and transparency”, with the well-being of infants its “highest priority”, it added.
Customers with questions or who need additional clarification may reach out to Nestlé Consumer Services at 800 6011 633.
Also read: SFA issues recall for fishball product due to undeclared egg allergen
SFA issues recall for fishball product due to undeclared egg allergen
Have news you must share? Get in touch with us via email at news@mustsharenews.com.
Featured image adapted from Nestlé FamilyNes Singapore on YouTube and Google Maps.





